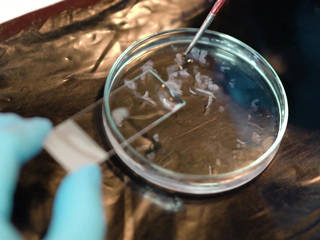

| ||
| Важное: Петербург | Ленинградская | Зенит | Медведев | Лукашенко | Футбол | Хоккей | НАТО | Путин | Рогозин | Аксенов | Глазьев | Газпром | Крым | Полтавченко | Пушков | ||
Искали недавно:
Медведев
НАТО
Путин
Футбол
Рогозин
Аксенов
Полтавченко
Лукашенко
Хоккей
Петербург
Крым
Зенит
Пушков
Газпром
Еще...
Новости. Общество
Попова: "омикрон" вызывает серьезные опасения
В Роспотребнадзоре рассказали об опасности "омикрона". Глава ведомства Анна Попова обратила внимание на то, что новая мутация вызывает серьезные опасения.
Подраздел: общество
Источник: https://www.vesti.ru/article/2646467
30.11.2021 18:22
Это и мой Крым: Лукашенко высказался о принадлежности полуострова
Лавров о Донбассе: надеюсь, там не повторится сценарий 2008 года
Президент назвал основную проблему России на ближайшие 10 лет
Наташа Королева не лишилась салона красоты
Зима наступает: в Москве и области выпадет 5-12 сантиметров снега
Рашкину сделали офтальмологическую операцию
Поисковые работы на "Листвяжной" приостановили из-за угрозы взрыва
Зимний шторм: ветер разогнался до рекордных значений
Врач: с появлением "омикрона" подъема заболеваемости не избежать
Залетный гость: желтый дождь с песком из Северной Африки прошел в Крыму
Генералов Росгвардии подозревают в хищениях
В России приняты допгарантии трудовых прав для ряда категорий работников
"Уговоры - не наш метод": "омикрон" почти везде, не только в Африке
Месси высказался о "Золотом мяче" и Левандовски
Еще...
| « | Октябрь, 2025 | » | ||||
| Пн | Вт | Ср | Чт | Пт | Сб | Вс |
| 1 | 2 | 3 | 4 | 5 | ||
| 6 | 7 | 8 | 9 | 10 | 11 | 12 |
| 13 | 14 | 15 | 16 | 17 | 18 | 19 |
| 20 | 21 | 22 | 23 | 24 | 25 | 26 |
| 27 | 28 | 29 | 30 | 31 | ||
Новости. Общество:
2023-01-23
05:47 Отказ ФРГ направить Киеву танки - признак глубоких разногласий в НАТО
05:23 Залог победы России - суверенная экономика
2023-01-20
05:07 Луговой: проводить трибунал - прерогатива победителей
2023-01-17
05:41 США готовы к долгому противостоянию с РФ за счет Украины и Европы
05:09 Дробницкий: Украина в конфликте с РФ выступает "аватаром" Запада
2023-01-11
05:28 Астахов: международное право не работает
05:09 Украина полностью зависит от западного вооружения
2022-12-27
05:48 Суверенитет России - угроза для Америки
05:13 Шахназаров: Россия имеет право не признавать Украину в границах 91-го года
2022-12-21
05:07 Симоньян заявила, что конфликт России с Западом - поворотный момент для мира
2022-12-15
03:56 России необходимо выстраивать реальность собственных ценностей
03:21 Эксперт призвал перестать комментировать каждое высказывание Зеленского
2022-12-12
04:45 В США до сих пор не отказались от идеи использования ядерного оружия
04:23 Россия получила технологическое преимущество перед Западом
2022-12-09
05:43 Эксперт объяснил, почему хотят запретить русскую культуру
05:07 Кедми призвал не ждать от Киева разумных решений
2022-12-06
04:41 Кедми заявил о легковесности европейских политиков
04:07 Канцлер Шольц примеряет на себя образ "своего парня" для США
2022-12-05
10:00 Нужна помощь: Никиту Печенкина спасет операция на позвоночнике
2022-11-30
04:45 Корнилов: НАТО пытается залезть в подбрюшье России через Украину
Page generated: 0.08